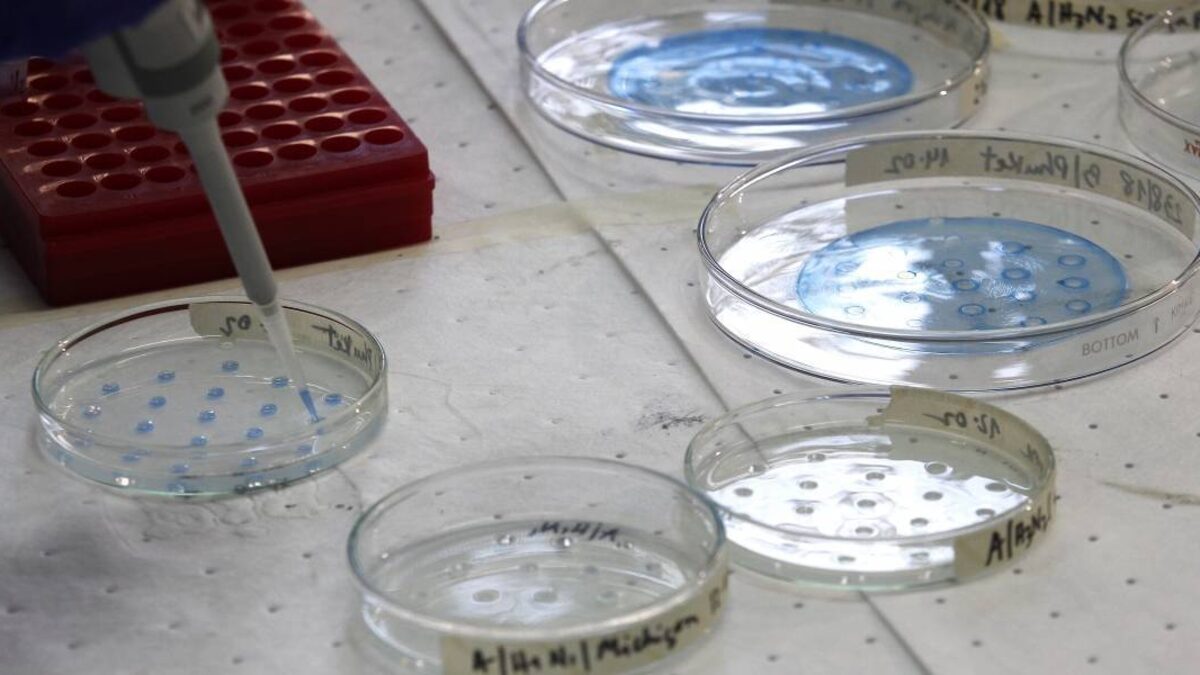

El Ministerio de Salud dio a conocer este sábado un nuevo reporte de casos de coronavirus en el país.
El subsecretario de Redes Asistenciales, Alberto Dougnac, señaló que en las últimas 24 horas se registraron 4.550 contagios de covid.
En ese sentido señaló que 2.760 casos son con síntomas, 1.597 asintomáticos y 193 no notificados.
La autoridad indicó además que se reportaron 68 fallecidos inscritos en las últimas 24 horas.
De esta manera, se contabilizan 17.854 decesos en Chile desde que se inició la crisis.
23 de enero | Red Asistencial #COVID_19
🔹 1.266 hospitalizados
🔹 1.062 en ventilación mecánica
🔹 88 críticos
🔹 183 camas críticas
🔹 58.428 exámenes PCR realizados (7.586.356 en total)#ResidenciasSanitarias
🔹 10.939 cupos
🔹 153 Residencias pic.twitter.com/h5UYmBEFCT— Ministerio de Salud (@ministeriosalud) January 23, 2021